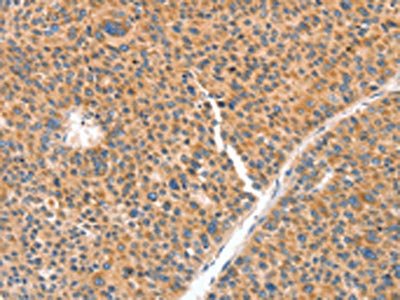

NUAK1 Antibody
-
中文名稱:NUAK1兔多克隆抗體
-
貨號:CSB-PA203867
-
規格:¥1100
-
圖片:
-
The image on the left is immunohistochemistry of paraffin-embedded Human lung cancer tissue using CSB-PA203867(NUAK1 Antibody) at dilution 1/70, on the right is treated with synthetic peptide. (Original magnification: ×200)
-
The image on the left is immunohistochemistry of paraffin-embedded Human liver cancer tissue using CSB-PA203867(NUAK1 Antibody) at dilution 1/70, on the right is treated with synthetic peptide. (Original magnification: ×200)
-
-
其他:
產品詳情
-
Uniprot No.:
-
基因名:NUAK1
-
別名:NUAK1 antibody; ARK5 antibody; KIAA0537 antibody; OMPHK1 antibody; NUAK family SNF1-like kinase 1 antibody; EC 2.7.11.1 antibody; AMPK-related protein kinase 5 antibody; ARK5 antibody; Omphalocele kinase 1 antibody
-
宿主:Rabbit
-
反應種屬:Human,Mouse
-
免疫原:Synthetic peptide of Human NUAK1
-
免疫原種屬:Homo sapiens (Human)
-
標記方式:Non-conjugated
-
抗體亞型:IgG
-
純化方式:Antigen affinity purification
-
濃度:It differs from different batches. Please contact us to confirm it.
-
保存緩沖液:-20°C, pH7.4 PBS, 0.05% NaN3, 40% Glycerol
-
產品提供形式:Liquid
-
應用范圍:ELISA,IHC
-
推薦稀釋比:
Application Recommended Dilution ELISA 1:2000-1:10000 IHC 1:100-1:300 -
Protocols:
-
儲存條件:Upon receipt, store at -20°C or -80°C. Avoid repeated freeze.
-
貨期:Basically, we can dispatch the products out in 1-3 working days after receiving your orders. Delivery time maybe differs from different purchasing way or location, please kindly consult your local distributors for specific delivery time.
-
用途:For Research Use Only. Not for use in diagnostic or therapeutic procedures.
相關產品
靶點詳情
-
功能:Serine/threonine-protein kinase involved in various processes such as cell adhesion, regulation of cell ploidy and senescence, cell proliferation and tumor progression. Phosphorylates ATM, CASP6, LATS1, PPP1R12A and p53/TP53. Acts as a regulator of cellular senescence and cellular ploidy by mediating phosphorylation of 'Ser-464' of LATS1, thereby controlling its stability. Controls cell adhesion by regulating activity of the myosin protein phosphatase 1 (PP1) complex. Acts by mediating phosphorylation of PPP1R12A subunit of myosin PP1: phosphorylated PPP1R12A then interacts with 14-3-3, leading to reduced dephosphorylation of myosin MLC2 by myosin PP1. May be involved in DNA damage response: phosphorylates p53/TP53 at 'Ser-15' and 'Ser-392' and is recruited to the CDKN1A/WAF1 promoter to participate in transcription activation by p53/TP53. May also act as a tumor malignancy-associated factor by promoting tumor invasion and metastasis under regulation and phosphorylation by AKT1. Suppresses Fas-induced apoptosis by mediating phosphorylation of CASP6, thereby suppressing the activation of the caspase and the subsequent cleavage of CFLAR. Regulates UV radiation-induced DNA damage response mediated by CDKN1A. In association with STK11, phosphorylates CDKN1A in response to UV radiation and contributes to its degradation which is necessary for optimal DNA repair.
-
基因功能參考文獻:
- NUAK1 is excessively expressed in NPC and may serve as a potential predictor of prognosis for NPC. PMID: 30121842
- The elevated ARK5 expression was closely associated with cancer metastasis and patient survival, and it seemed to function in Gastric Cancer cells migration and invasion via epithelial-mesenchymal transition alteration, together with the alteration of the mTOR/p70S6k signals, Slug and SIP1. PMID: 28662499
- ARK5 confers doxorubicin resistance in hepatocellular carcinoma by inducing epithelial-mesenchymal transition. PMID: 27126361
- Nuak1 downregulation decreases tau levels in a human cell line. PMID: 27720485
- High NUAK1 expression are correlated with epithelial-mesenchymal transition induction in head and neck cancer. PMID: 26882562
- ARK5 was upregulated in ovarian cancer tissues, promoted epithelialmesenchymal transition and inhibited miR-1181 expression in ovarian cancer cells PMID: 26151663
- MiR-145 functions as a tumor suppressor targeting NUAK1 in human intrahepatic cholangiocarcinoma. PMID: 26255969
- Overexpression of NUAK1 is associated with disease-free survival and overall survival in patients with gastric cancer. PMID: 24943992
- Data indicate that miR-96 suppresses the expression of (nua) kinase family 1 (NUAK1) by targeting its 3' untranslated region (3' UTR). PMID: 25242509
- Results indicate that NUAK1 is excessively expressed in NSCLC and plays important roles in NSCLC invasion. PMID: 25412236
- Expression of NUAK1 is controlled by cyclin-dependent kinase, PLK1, and the SCFbetaTrCP (Skp, Cullin and F-boxbetaTrCP) E3 ubiquitin ligase complex. PMID: 24785407
- We demonstrate that miR-211 contributes to melanoma adhesion by directly targeting a gene, NUAK1. PMID: 23934065
- Overexpression of ARK5 is associated with hepatocellular carcinoma. PMID: 23516026
- High NUAK1 expression correlates with poor prognosis and involved in human nonsmall cell lung cancer cells migration and invasion. PMID: 23215946
- ARK5 can promote glioma cell invasion by regulating cytoskeleton rearrangement and matrix metalloproteinase activation. PMID: 23063350
- in human and murine cell lines, oncogenic levels of MYC establish a dependence on AMPK-related kinase 5 for maintaining metabolic homeostasis and for cell survival; ARK5 is an upstream regulator of AMPK and limits protein synthesis via inhibition of the mammalian target of rapamycin 1 (mTORC1) signalling pathway PMID: 22460906
- ARK5 enhanced the invasive and metastatic potential of MDA-MB-231 cells under regulation by Akt. PMID: 22105900
- NUAK1 and PPP1CC are identified as positional candidate loci for skeletal muscle strength phenotypes. PMID: 21750233
- A novel role for NUAK1 in LKB1-related signaling pathways; NUAK1 can regulate cell proliferation and exert tumor suppression through direct interaction with p53. PMID: 21317932
- the LKB1-NUAK pathway has roles in controlling myosin phosphatase complexes and cell adhesion PMID: 20354225
- Cells that constitutively express NUAK1 suffer gross aneuploidies and show diminished expression of the genomic stability regulator LATS1, whereas depletion of NUAK1 with shRNA exerts opposite effects. PMID: 19927127
- Data suggest that a novel AMPK family member, ARK5, is the tumor cell survival factor activated by Akt and acts as an ATM kinase under the conditions of nutrient starvation. PMID: 12409306
- ARK5 suppresses the apoptosis induced by nutrient starvation and death receptors via inhibition of caspase 8 activation. PMID: 13679856
- Results report that a novel AMPK catalytic subunit family member, ARK5, plays a key role in tumor malignancy downstream of Akt. PMID: 15060171
- ARK5 negatively regulates procaspase-6 by phosphorylation at Ser257, leading to resistance to the FasL/Fas system. PMID: 15273717
- overexpression of ARK5 is associated with tumor invasion and metastasis PMID: 15354411
- ARK5 is a transcriptional target of the Large-MAF family through MARE sequence and that ARK5 may in part mediate the aggressive phenotype associated with c-MAF- and MAFB-expressing myelomas PMID: 16044163
- NDR2 is an upstream kinase of ARK5 that plays an essential role in tumor progression through ARK5 PMID: 16488889
顯示更多
收起更多
-
亞細胞定位:Nucleus. Cytoplasm.
-
蛋白家族:Protein kinase superfamily, CAMK Ser/Thr protein kinase family, SNF1 subfamily
-
組織特異性:Expressed at high levels in heart and brain, and at lower levels in skeletal muscle, kidney, ovary, placenta, lung and liver. Highly up-regulated in colorectal cancer cell lines.
-
數據庫鏈接:
Most popular with customers
-
-
YWHAB Recombinant Monoclonal Antibody
Applications: ELISA, WB, IHC, IF, FC
Species Reactivity: Human, Mouse, Rat
-
Phospho-YAP1 (S127) Recombinant Monoclonal Antibody
Applications: ELISA, WB, IHC
Species Reactivity: Human
-
-
-
-
-